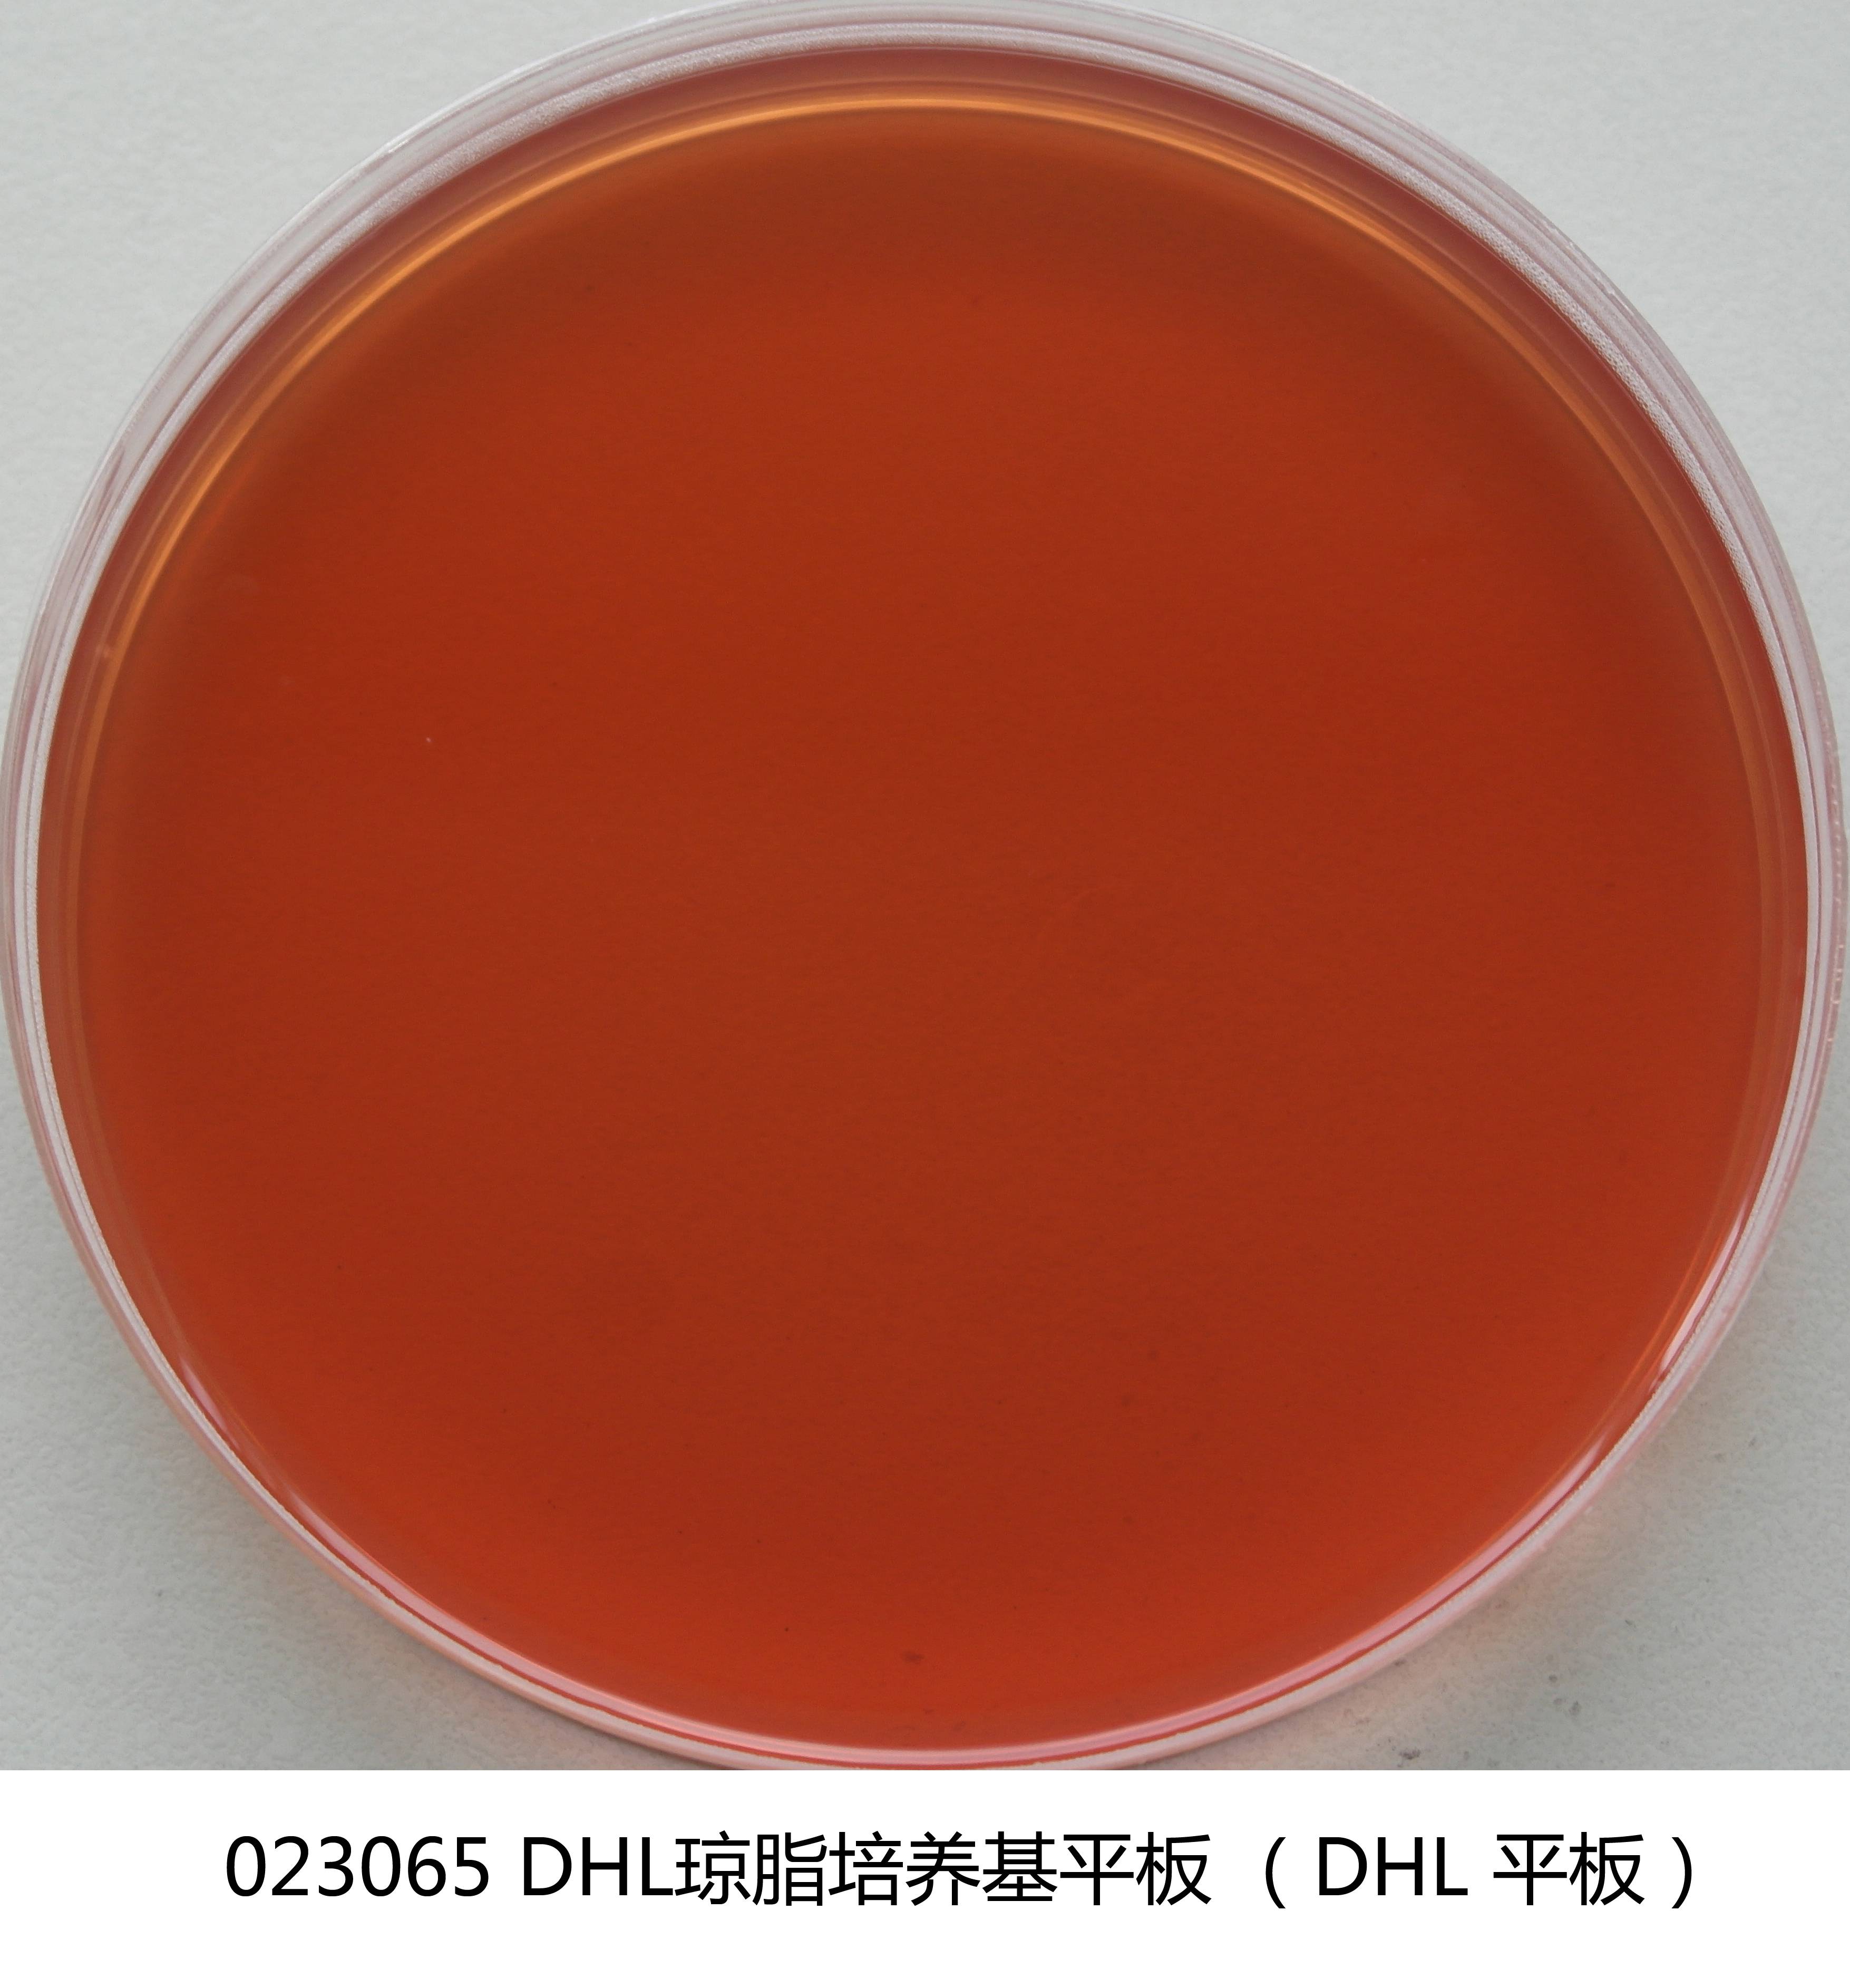
胆硫乳(DHL)琼脂平板

商品详细
说明书
微生物图册
行业应用
相关论文
产品名称:胆硫乳(DHL)琼脂平板
英文名称:Deoxycholate Hydrogen Sulfied Lactose Agar Plate
产品编号与包装规格:
| 产品编号 | 产品类型 | 包装规格 |
|---|---|---|
| 023065 | 即用型成品平板 | 90mm×20个/盒 |
产品用途:用于肠道致病菌特别是沙门氏菌和志贺氏菌的选择性分离培养。
配方成分:蛋白胨、牛肉膏粉、乳糖、蔗糖、去氧胆酸钠、琼脂、硫代硫酸钠、柠檬酸钠、柠檬酸铁铵、中性红、蒸馏水(pH 值:7.3±0.2)。
注意事项:储存温度需保持恒定(请尽量选择接近使用环境的温度存放),避免温差过大;不建议长期存放于2-8℃冰箱中。
储存条件: 2-25℃避光保存;有效期见标签说明。
023065 胆硫乳(DHL)琼脂平板 产品更多详情可查看 干粉 023060 DHL琼脂(胆硫乳琼脂) 250g/瓶 。
